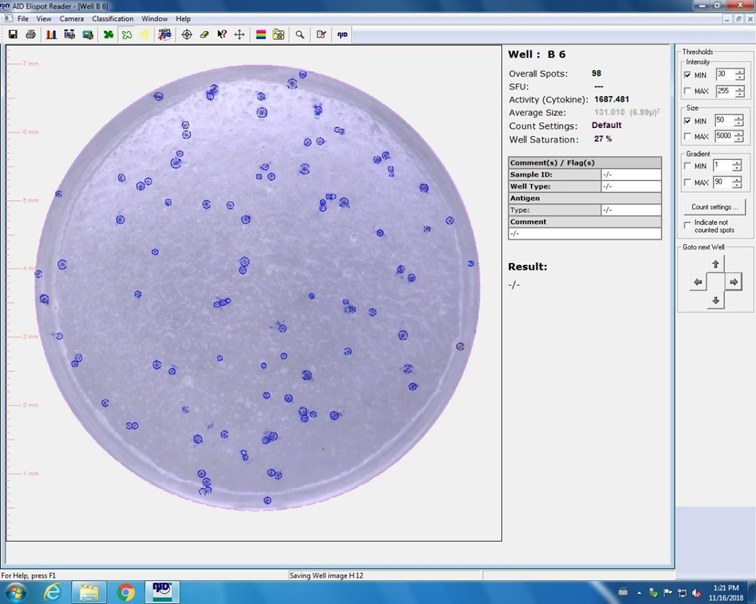

Advanced Search
Last updated date: Jul 19, 2021 Views: 745 Forks: 0
Foci Reduction Neutralization Test (FRNT) for Determining Antibodies against Arboviruses via ELISPOT read-out
I. PRINCIPLE
A variety of serological tests have been used to measure antibodies targeting arboviruses. These tests include the hemagglutination-inhibition test (HI), complement fixation test (CF), indirect fluorescent antibody test (IFA), enzyme-linked immunosorbent assay (ELISA), and neutralization tests (NTs). Only NTs measure the biological parameter of in vitro virus neutralization and are the most serologically virus- specific test among arboviruses, and even serotype-specific among dengue viruses. For the NTs the amount of infected cells could be detected by two different strategies: (i) based on the cytopathic effect (CPE) of infected cells could be measured as plaques, then the assay is an plaque reduction neutralization test (PRNT); (ii) based on immunostaining of infected cells with virus-specific detection antibodies where infected cells are visible as foci and the assay is called foci reduction neutralization test (FRNT). The latter one is faster, more reliable and can be performed in smaller wells than the PRNT.
Neutralization tests are the current laboratory standard for measuring neutralizing antibody. The basic design of the FRNT allows for virus-antibody interaction to occur in a test tube or microtiter plate, and then measuring antibody effects on viral infectivity by plating the mixture on virus-susceptible cells (e.g. LLC-MK2 or Vero). The serum specimen being tested is usually subjected to serial dilutions prior to mixing with a constant amount of virus. After incubation, when the infection takes place, the cells were overlaid with a semi-solid media that restricts spread of progeny virus. Each virus that initiates a productive infection, produces a focus stained via virus-specific antibodies. The foci in the wells incubated with serum-virus mixtures were counted and compared back to the starting concentration of virus to determine the percent reduction in total virus infectivity. In this way, FRNT end-point titers can be calculated for each serum specimen at any selected percent reduction of virus activity.
These procedures describe the method for determination of neutralizing antibodies against arboviruses like Dengue virus (DENV), Japanese encephalitis virus (JEV), Zika virus (ZIKV), Yellow fever virus (YFV), West Nile virus (WNV), or Chikungunya virus (CHIKV). The DENV serotype can be determined if the FRNT is performed against all four DENVs separately.
II. REAGENTS, MATERIAL and EQUIPMENT
| Material/equipment | Supplier/model | Location |
| Pipette aid | Drummond |
Cell culture laboratory |
| Serological pipettes 5ml, 10ml, 25ml | Falcon | |
| 96well cell culture plate (flat bottom) | Costar (Corning Incorporated) | |
| TECH Gloves quality with powder | Intermedica co, LTD | |
| Humidified incubator with 5% CO2 atmosphere |
Thermo Scientific | |
| Biosafety cabinet | FASTER | |
Pipetts : Gilson P20 Gilson P200 Gilson P1000 |
Gilson |
P2 arbovirology laboratory |
| Multipipette 0-300μl | Nichiryo, Nichipet 7000 | |
| Automatic multi-pipette | Eppendorf, Xplorer plus | |
| Barrier tips 10ul, 20ul, 200ul, 1000ul | Neptune | |
| Reaction tube 50ml | Sarstedt | |
| Vortex | Fisher Scientific, TopMix FB15013 | |
| 96well U-bottom plate | Falcon (Corning Incorporated) | |
| Solution basin, 55ml | Heathrow Scientific | |
| TECH Gloves quality with powder | Intermedica co, LTD | |
| Humidified incubator with 5% CO2 atmosphere |
Thermo Scientific | |
| Biosafety cabinet | FLUFRANCE | |
| Water bath | Serology laboratory | |
| ELISPOT Reader ELRIFL06 | AID Diagnostics GmbH | Immunology laboratory |
| Solutions/Reagents | Components |
| Growth medium for Vero cells | 94% DMEM 5% Fetal Bovine Serum (FBS; heat-inactivated) 1% antibiotics (50000 UI/ml penicillin & 50000 µg/ml streptomycin) |
| Diluent for sera and virus dilutions | DMEM (NO supplements) |
Overlay medium | 5% (w/v) carboxymethyl cellulose (CMC, low viscosity); powder sterile autoclaved and afterwards solved in growth medium (94% DMEM, 5% FBS, 1% antibiotics) |
| Washing solution (non-sterile) | PBS 1x |
| Inactivation solution (non-sterile) | 4% formaldehyde in PBS 1x |
| Permeabilization solution (non-sterile) | 0.5% Triton X-100 in PBS 1x |
| Blocking solution | 10% FBS in sterile PBS 1x |
Primary antibody solution | polyclonal mouse ascites hyper-immune fluids: DENV1 diluted 1:2,000 in blocking solution (batch: 01As01) DENV2 diluted 1:2,000 in blocking solution (batch: 01As02) DENV3 diluted 1:2,000 in blocking solution (batch: 07As01) DENV4 diluted 1:2,000 in blocking solution (batch: 01As04) ZIKV diluted 1:2,000 in blocking solution (batch: As 2015-01) JEV diluted 1:2,000 in blocking solution (batch: 2014As01) CHIKV diluted 1:2,000 in blocking solution (batch: 97As01) |
| Secondary antibody solution | anti-mouse HRP-conjugate (Biorad, #172-1011) diluted 1:2,000 in blocking solution |
| TMB substrate | KPL’s TrueBlue (#71-00-64) |
III. PROCEDURE
1. Virus preparation (see SOP Arbovirus Titration by Foci Assay)
1.1. Cultivation generally on C6/36 cells to achieve higher virus titers
1.2. Optional: PEG precipitation of the virus to increase the concentration
1.3. Determining the virus concentration via foci forming assay (FFA)
2. Preparation of Vero cells
2.1. Seed in 96well plates 200μl of cell suspension in growth medium
• Vero cells: 3*10^4 cells per well (suspension: 2*10^5 cells/ml and 150 µL/well)
cells will form 100% confluent monolayer overnight at 37 , 5% CO2 incubator
3. Preparation of serum dilution
3.1. Sera had to be heat-inactivated at 56°C for 30 min before the preparation of the dilutions
3.2. Label 96 well round-bottom plate with serum IDs (or short numbers)
3.3. Prepare serial serum dilution in 96well round-bottom plate(s) in DMEM (no supplements required)

Figure 1: Dilution plate
Table 1: Serum dilutions
| Lane | 1 | 2 | 3 | 4 | 5 | 6 | 7 | 8 | 9 | 10 |
| Diluent (µL) | 162 | 90 | 90 | 90 | 90 | 90 | 90 | 90 | 90 | 90 |
| Test sera (µL) | 18 | - | - | - | - | - | - | - | - | - |
Amount of prior dilution (µL) | - | 90 | 90 | 90 | 90 | 90 | 90 | 90 | 90 | 90 |
| Dilution factor | 10 | 20 | 40 | 80 | 160 | 320 | 640 | 1280 | 2560 | 5120 |
• Do NOT forget to remove 90μL from last serum dilution (lane 10)!
• Negative control I (virus): lanes 11 and 12 remain serum-free (only filled with 90μL DMEM) as control for each tested serum (reference value for ffu calculation)
• Negative control II (serum): serum that is negative for arbovirus antibodies diluted in the same way like shown in table 1 and figure 1 (one row of dilutions is sufficient for 3 plates (= 6 tested sera))
4. Preparation of a virus dilution in order to get a concentration of 4,000 ffu/mL (= 100 foci per well)
• Calculate with 2.5mL virus dilution per tested sera
• Dilute virus in DMEM (no supplements required)
5. Preparation of the back titration from virus dilution in the 96well round-bottom dilution plate (see row H figure 1) → back titration is used as control for the initial virus dilution (4,000 ffu/mL)
• Prepare serial serum dilution in 96well round-bottom plate as shown in Table 2:
Table 2 Virus back titration
| Lane | 1 | 2 | 3 | 4 | 5 | 6 | 7 | 8 | 9 | 10 |
| Diluent (µL) | 170 | 170 | 170 | 170 | 170 | 170 | 170 | 170 | 170 | 170 |
Original virus dilution (µL) | 170 | - | - | - | - | - | - | - | - | - |
Amount of prior dilution (µL) | - | 170 | 170 | 170 | 170 | 170 | 170 | 170 | 170 | 170 |
| Dilution factor | 1 | 2 | 4 | 8 | 16 | 32 | 64 | 128 | 256 | 512 |
• Do NOT forget to remove 170μL from last serum dilution!
• Negative control III (cells): lanes 11 and 12 remain virus-free and serum-free only filled with 170μL DMEM
6. Serum-virus mixtures (neutralization)
6.1. Add an equal volume of 90µL of the diluted virus to each of the serum dilutions/medium
6.2. Incubate the dilution plate(s) and the remaining virus dilution in the incubator at 37°C, 5% CO2 for 1h (allow antibody-mediated neutralization of virus)
Table 3 Requirements of dilution and inoculation plates
| Amount of samples | 6 | 8 | 12 | 16 | 20 | 24 |
| Amount of dilution plates (round-bottom 96well) | 1 | 2 | 2 | 3 | 4 | 4 |
| Amount of lanes of negative control serum in dilution plate | 1 | 2 | 2 | 3 | 4 | 4 |
| Amount of lanes of virus back titration in dilution plate | 1 | 2 | 2 | 3 | 4 | 4 |
| Amount of inoculation plates (flat-bottom 96well with cells) | 3 | 4 | 6 | 8 | 10 | 12 |
7. Inoculation of serum-virus mixture onto cells (infection):
7.1. Discard all growth medium from 96well cell plates
7.2. Add 50µL of each virus-serum mixture onto each well of cell monolayer
7.3. Add 50µL of back titrated virus dilution into respective wells of cell monolayer (see Figure 2)
7.4. Incubate the inoculated plates in the incubator at 37°C, 5% CO2 for 1h (allow the non-neutralized virus particles absorption on the cells)
7.5. After the incubation period, remove the inoculums and add 150μL of overlay medium into each well
7.6. incubate the plates in the wells in the incubator at 37 °C, 5% CO2
Do NOT move the plates during incubation!

Figure 2: Inoculation plate
Table 4 Incubation periods of arbovirus FRNTs until staining
| Virus | Strain | Incubation period |
| Dengue virus serotype 1 (DENV-1) | Hawaii | 3d p.i. |
| Dengue virus serotype 2 (DENV-2) | New Guinea C | 2d p.i. |
| Dengue virus serotype 3 (DENV-3) | H87 | 2d p.i. |
| Dengue virus serotype 4 (DENV-4) | H241 | 1d p.i. |
| Zika virus (ZIKV) | MR766 | 1d p.i. |
| FSS13025 | 1d p.i. | |
| HD78788 | 1d p.i. | |
| Dak84 | 1d p.i. | |
| MRS-OPY | 1d p.i. | |
| MAS66 | 1d p.i. | |
| NC-2014-5132 | 1d p.i. | |
| Japanese encephalitis virus (JEV) | Nakayama | 1d p.i. |
| Chikungunya virus (CHIKV) | NC-2011-568 | 1d p.i. |
| TH35 | 1d p.i. | |
| 1455-75 | 1d p.i. | |
| V1024306_KH11_PVH | 1d p.i. |
8. Staining:
8.1. After the determined incubation time, add 150μL of inactivation solution (Formaldehyde) into each well
8.2. incubate plates at room temperature (20-25°C) for 30min
8.3. Discard the solution by turning plates upside down and shake out supernatant into biohazard liquid waste container and clean plates with Anioswipes
8.4. Wash the cells twice by adding 200µL of non sterile1x PBS, discard washing solution→ After this step, further staining can be performed outside biosafety cabinet
8.5. Add 50μL of permeabilization solution (Triton) per well
8.6. Incubate plates at room temperature for 15-20min
8.7. Discard the solution by turning plates upside down and shake out supernatant
8.8. Wash the cells by adding 200µL of non sterile1x PBS, discard washing solution
8.9. Add 50μL of blocking solution (FCS) per well
8.10. Incubate plates at room temperature for 30min (or overnight at 4°C)
8.11. Discard the solution by turning plates upside down and shake out supernatant → DO NOT wash the plate(s)
8.12. Add 50μL of primary antibody solution per well
8.13. Incubate plates at room temperature for 1h (or overnight at 4°C)
8.14. Discard the solution by turning plates upside down and shake out supernatant
8.15. Wash the cells by adding 200µL of non sterile1x PBS, discard washing solution
8.16. Add 50μL of secondary antibody solution (HRP conjugate) per well
8.17. Incubate plates at room temperature for 1h
8.18. Discard the solution by turning plates upside down and shake out supernatant
8.19. Wash the cells by adding 200µL of non sterile1x PBS, discard washing solution
8.20. Add 30μL of TMB substrate per well
8.21. Incubate plates at room temperature for 10-15 min
8.22. Discard the solution by turning plates upside down and shake out supernatant
8.23. Count the foci or scan the plates immediately (optional store plates in the dark at 4°C)
9. Analysis
9.1. Foci counting with AID ELISPOT reader
9.1.1. Turn on ELISPOT reader and the lamp (2 turn on switches)
9.1.2. Place 96well plate without the lid into the reader with a white paper as background

9.1.3. Before the first read, load stage calibration (or create a new calibration):→Stage can be used for read-out of all
plates at one read-out time
9.1.4. Set-up of count settings:
Start with the following settings and adapt if necessary
• Intensity min 25 (±5)
• Size min 50 (±5)
• Emphasis big
• Algorithm C

After adapting count settings for the first plate use this settings for reading all plates of the same experimental batch

9.1.5. Start plate analysis:

9.1.6. Check foci count for single wells by selecting single well pictures via double click on respective well
9.1.7. Foci counts for individual wells can be adapted by
• Deleting (erase) or

• adding foci manually

9.1.8. After analysis of complete plate, save plate data with “Save as”function:
9.1.9. Export data into excel file (by EliStat export):
9.2. Data collection in excel file
9.2.1. Copy data (=counted foci) from export excel file into single data file (use provided template)

9.2.2. Use template for automatically calculation of mean and standard deviation as well as visualization of your data, e.g.:

9.3. Calculation of FRNT titers with SPSS
9.3.1. Copy and paste mean counts from excel file into SPSS data sheet (use template)

9.3.2. Log-probit analysis: Analyze
Regression →Probit

9.3.3. Output file:

IV. INTERPRETATION OF RESULTS
The neutralizing activity of a test serum is determined by its ability to reduce the number of virus foci compared to the number seen in negative controls. As negative controls act row A in every inoculation plate (negative serum with virus; see figure 2) as well as the lanes 11 and 12 in each inoculation plate (virus only). Additionally, the virus concentration used for infection/neutralization can be controlled by using the back titration calculation*. A reduction of plaque count of 50% is taken as the neutralizing end point (FRNT50 titer). A reduction of plaque count of 90% is taken as the neutralizing end point (FRNT90 titer).
* calculation of virus concentration:
𝑓𝑓𝑢/ 𝑚𝑙 = 𝑐𝑜𝑢𝑛𝑡𝑒𝑑 𝑓𝑜𝑐𝑖 𝑖𝑛 𝑜𝑛𝑒 𝑑𝑖𝑙𝑢𝑡𝑖𝑜𝑛 𝑤𝑒𝑙𝑙 ∙ 𝑑𝑖𝑙𝑢𝑡𝑖𝑜𝑛 𝑓𝑎𝑐𝑡𝑜𝑟 𝑜𝑓 𝑡ℎ𝑖𝑠 𝑤𝑒𝑙𝑙 ∙ 40
e.g. 16 foci counted in well H2 (= dilution factor 2): 16 ∙ 2 ∙ 40 = 1280 𝑓/𝑓𝑢 𝑚𝑙
Determine the FRNT50 or FRNT90 titer by linear regression (probit) analysis using either probit paper or a computer software program, or determine highest dilution that results in ≤50% or ≤90% of input plaque count respectively.
Do you have any questions about this protocol?
Post your question to gather feedback from the community. We will also invite the authors of this article to respond.
Share
Bluesky
X
Copy link